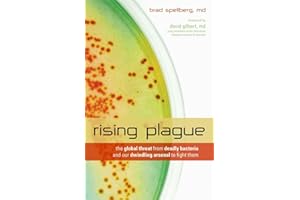
Rising Plague: The Global Threat from Deadly Bacteria and Our Dwindling Arsenal to Fight Them

DEADLY THREAT best sellers
Get a list of 32 DEADLY THREAT best sellers on Amazon, Ebay and Walmart . Period is past 7 days, last updated 2025-01-06.

|
#1 Force Recon Ghost Camo $199 on Ebay |
|

|
#2 Urban Assault Ghost Camo $289 on Ebay |
|

|
#3 🔥 Urban Assault Full Tactical $134.95 on Ebay |
|

|
#4 🔥 Urban Assault Black Storm $289 on Ebay |
|

|
#5 Tactical Vest Plate Carrier $88 on Ebay |
|

|
#6 Urban Assault Desert $134.99 on Ebay |
|

|
#7 Urban Assault Desert $289 on Ebay |
|

|
#8 Urban Assault Black Storm $134.95 on Ebay |
|

|
#9 Urban Assault Black Storm $244 on Ebay |
|

|
#10 What If? Experts' Survival $20.69 on Amazon |
|

|
#11 The Asteroid Threat $19.60 on Amazon |
|

|
#12 Rising Plague The Global $23.16 on Amazon |
|

|
#13 Rising Plague The Global $37.71 on Amazon |
|

|
#14 Rising Plague The Global $20.21 on Amazon |
|

|
#15 Rising Plague The Global $19.31 on Amazon |
|

|
#16 Rising Plague The Global $22.53 on Amazon |
|

|
#17 Rising Plague The Global $23.41 on Amazon |
|

|
#18 Rising Plague The Global $25.86 on Amazon |
|

|
#19 Rising Plague The Global $23.38 on Amazon |
|
|
#20 Rising Plague The Global $20.21 on Amazon |
Suggested best sellers
What's in Bestsellers.ai PRO ?
- 📊 Product Sales Estimates
- 💰 Total Sales Estimates
- 📜 Product Sales history
- 📅 52-Week Sales estimates
- 🔍 Advanced filtering
- ♻️ Second Hand and Refurbished market Data
Who uses Bestsellers.ai PRO ?
Trusted by e-merchants everywhere, Bestsellers.ai is their go-to for deciding what to sell next. Leading brands and retailers rely on us for crucial competitor insights and data-driven choices. 🚀
